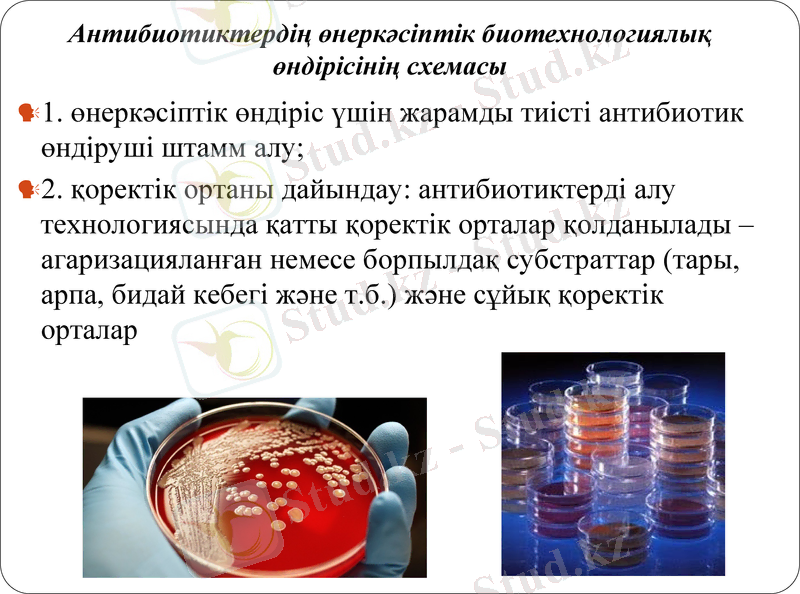
Slide 15

Эритромицин өндіретін рекомбинантты штамм-продуценттерді алу әдістері және антибиотиктердің биотехнологиялық өндірісі



Антибиотиктердің (эритромицин) рекомбинантты штамм-продуценттерді алу әдістері.
Орындаған: Жангельді А.

Антибиотиктердің жалпы сипаттамасы
"Антибиотик" терминін 1942 жылы Зельман Абрахам Ваксман микроорганизмдер түзетін және микробқа қарсы әсері бар заттарға сілтеме жасау үшін ұсынған.
Антибиотиктердің дамуы мен өндірісі XIX ғасырдың соңында белсенді түрде басталды. Өнеркәсіптік өндіріске алғашқы антибиотик сальварсан болды (1910) .
Антибиотиктер-бұл микроорганизмдер синтездейтін және тірі жасушалардың өсуін өлтіруге немесе басуға қабілетті жоғары тиімді биологиялық белсенді заттар тобы.

Антибиотиктердің жіктелуі
Бактериялық жасушаға әсер ету сипаты бойынша антибиотиктерді үш топқа бөлуге болады:
- бактериостатикалық
- бактерицидтер
- бактериолитикалық

Антибиотиктердің жіктелуі
Биологиялық әсер ету механизміне сәйкес антибиотиктер бөлінеді:
1. Бактериялық қабырға синтезін тежейтін антибиотиктер
2. Цитоплазмалық мембрананың жұмысын бұзатын антибиотиктер
3. Рибосомалық қосалқы бөлшектерді бұзатын және ақуыз синтезін тежейтін антибиотиктер
4. Нуклеин қышқылдарының синтезін таңдамалы түрде басатын антибиотиктер:
- РНҚ синтезінің тежегіштері
- ДНҚ синтезі тежегіштері

- лактамдық (пенициллиндер, цефалоспориндер) ;
- тетрациклиндер (тетрациклин, морфоциклин, метациклин) ;
- макролидтер (эритромицин) ;
- аминогликозидтер (гентамицин) ;
- гликопептидтер (ванкомицин) ;
- амфениколдар (левомицетин) ;
- линкосамидтер (линкомицин) ;
- Полиен (зеңге қарсы-нистатин) ;
- ісікке қарсы (блеомицин) және т. б.
Химиялық сипатына байланысты антибиотиктер бөлінеді:

Антибиотиктерді штамм-продуценттер бойынша жіктеу:
Өндіруші ағзаларға байланысты антибиотиктерді келесі топтарға бөлуге болады:
1. Эубактериялар түзетін бактериялар: * Bacillus текті бактериялар: грамицидиндер, полимиксиндер және т. б. ;
• Pseudomonas текті бактериялар: мупироцин, пиоцианин, антифунгин және т. б. ;
• басқа текті бактериялар (Micrococcus, Streptococcus, Escherichia, Proteus) : низин, колиформин және т. б.
2. Бактериялар түзетін Streptomyces: стрептомицин, тетрациклин, новобиоцин және т. б.
3. Жетілмеген саңырауқұлақтардан түзілген: пенициллин, гризеофулвин және т. б.
4. Базидио - және аскомицет класының саңырауқұлақтарынан түзілген: термофиллин, лензитин, хетомин және т. б.
5. Жоғары өсімдіктер түзетін: аллицин, рафанин және т. б.
6. Жануарлар организмдерінде түзілетін: лизоцим, интерферон, круцин және т.

Антибиотиктер өндірушілер
Антибиотиктерді өндіруші ретінде микроорганизмдер, зең саңырауқұлақтары, актиномицеттер, жоғары өсімдіктер мен жануарлар тіндері қолданылады. Бір түрдің микроорганизмдері әртүрлі сипаттағы антибиотиктерді синтездей алады және керісінше, бірдей антибиотик әртүрлі таксономиялық топтардың микроорганизмдерін шығара алады. Эубактериялардың ішінде көбінесе өндірушілер Bacillus және Pseudomonas ұрпақтарының өкілдері болып табылады, бактериалды антибиотиктердің көпшілігі полипептидтер болып табылады.

Микроорганизмдер-антибиотиктер өндірушілер.
Актиномицеттер-бұл көп жасушалы бактериялар. Актиномицеттерде ядро жоқ, яғни актиномицеттер-прокариоттар, митохондрия жоқ, күрделі даму циклі бар.
Актиномицеттер антибиотиктердің келесі топтарын шығарады: (барлық белгілі 50% - дан кем емес),
-канамицин-Actinomyces kanamycetus
- неомицин-Actinomyces iracie
- окситетрациклин-Аctinomyces ninesus
- линкомицин-Streptomyces linconiensis
Табиғи левомицетин (хлорамфеникол) Streptomyces venezuelae шығарады.
Рифамицин-Streptomyces mediterranei, рифамицин негізінде рифампицин алынды.

Беталактамдық антибиотиктер өндіретін мицелиалды саңырауқұлақтар.
Пенициллиндер-мицелиалды саңырауқұлақтар шығаратын бета-лактамды антибиотиктердің белгілі өкілдері. Антибиотик құрылымында жасуша қабырғасының пептидогликандарының синтезін тежейтін қабілеті бар бета-лактамды сақина бар. Антибиотиктер бактериялардан туындаған инфекцияларды емдеуде қолданылады.
Фторхинолондар-синтетикалық антибиотиктер. Олардың кең спектрі барантимикробтық әсер. бактерияға қарсы ғана емес, сонымен қатар ісікке қарсы, АИТВ-ға қарсы белсенділігі де бар.

Жануарлардан шыққан антибиотиктер. Бекіре балықтарынан бөлінген Экмолин
, эритрин-эритроциттерден,
лизоцим және интерферон
Жоғары өсімдіктер шығаратын антибиотиктер - ұшпа. Бұл сарымсақ аллицині-Allium sativum, Сент-Джон сусланы иманині, шалфей сальваны, шалғам рафанині-Raphanus sativum, бұршақ фазеолині-Phaseolus vulgaris және басқалары

Методы получения антибиотиков:
1. Химиялық синтез. Бұл әдіспен негізгі синтетикалық антибиотиктер алынады.
2. Биосинтез (микроорганизмді-продуцентті тікелей ферменттеу) . Антибиотиктерді алу үшін антибиотиктің ең көп мөлшерін құрайтын микроорганизмдердің штамдары қолданылады.
3. Мутациялық биосинтез-антибиотиктердің синтезіне әкелетін реакциялар тізбегінде белгілі бір байланысы жоқ немесе блокталған мутанттарды қолдана отырып, антибиотиктердің биосинтезі.

рднк-антибиотиктерді жасаудағы биотехнология
рДНК-биотехнологиялар-антибиотик продуценттерінің белсенділігі жоғары штаммдарын жасау.
Рднқ көмегімен сіз минималды жанама әсерлері бар белгілі бір микроорганизмдерге күшті әсер ететін ерекше құрылымы бар жаңа антибиотиктер жасай аласыз.

Екінші метаболиттердің биосинтезі
Қайталама метаболиттер продуценттерінің микроорганизмдерінің даму процесі екі фазалық сипатқа ие:
дамудың бірінші кезеңі (тропофаза немесе теңдестірілген өсу фазасы) антибиотик өндірушісінің мәдениетінде биомассаның тез жинақталуымен сипатталады. Осы кезеңде антибиотик биосинтезі болмайды немесе аз мөлшерде жүзеге асырылады. Бұл фаза тез және қоректік орта арзан болуы керек.
екінші кезең (идиофаза немесе теңгерімсіз өсу фазасы) - идиофаза кезінде биомассаның өсуі баяулайды және культуралық сұйықтықта антибиотиктің тез жиналуы байқалады.

1-трофофаза, II - идиофаза, 1 -биомасса, 2-антибиотик, 3 - көмірсулар, 4-азот көзі
Антибиотиктердің өнеркәсіптік биотехнологиялық өндірісінің схемасы
1. өнеркәсіптік өндіріс үшін жарамды тиісті антибиотик өндіруші штамм алу;
2. қоректік ортаны дайындау: антибиотиктерді алу технологиясында қатты қоректік орталар қолданылады - агаризацияланған немесе борпылдақ субстраттар (тары, арпа, бидай кебегі және т. б. ) және сұйық қоректік орталар

3. Тұқым дайындау(мутантты өндірушілер тербелмелі колбаны бірінші инокуляторды (10 л) екінші инокуляторды (100-500 л) ферментерді алу) .

4. Ашыту: антибиотиктерді алу үшін үстірт және терең өсіру әдістері қолданылады. Ашыту кезінде культура стерильді қыздырылған ауамен үздіксіз аэрацияланады. Ашыту процесі қатаң стерильді терең аэробты мерзімді культурада жүзеге асырылады, айқын екі фазалы. Ортаның температурасы, рН және басқа да бірқатар параметрлер антибиотик өндірісінің регламентіне сәйкес автоматты түрде реттеледі. Антибиотиктер асептикалық жағдайда мерзімді әсер ететін терең аэробты ашыту арқылы алынады. Ашыту кезеңі 7-10 жылға созыладытәулік.

5. Антибиотиктерді бөлу. Егер антибиотик жасушаларда болса, өңдеудің бірінші кезеңінде биомасса культуралық сұйықтықтан шығарылады (сүзу немесе центрифугалау арқылы) ;
жасушалар жойылғаннан кейін антибиотик алынып, еритін фазаға ауыстырылады. Содан кейін бұл ерітінді мен культуралық орта (егер антибиотик жасушалардан ортаға шығарылса) дайын өнімді алу үшін экстракция, бөлу, тазарту және концентрациялаудың әртүрлі әдістеріне ұшырайды.

6. Антибиотиктерді тазарту. қамтитын кезеңдері: тұндыру, сорбция, кептіру. Содан кейін препарат стерильділікке кепілдік беретін шарттарды сақтай отырып, стерильді құтыларға оралады.
7. Дайын өнімді алу: дайын өнім биологиялық және фармакологиялық бақылаудан өтеді. Биологиялық бақылау препараттың стерильділік дәрежесін анықтайды. Фармакологиялық бақылау кезінде препараттың уыттылығына, пирогендігіне, токсикогенділігіне және т. б. жан-жақты сынақтар жүргізіледі, препараттың микробқа қарсы спектрін, қанның лейкоциттеріне әсерін бағалайды, антибиотиктің барынша көтерілетін дозасын, тәжірибелік жануарлардың толық және 50% өлімін тудыратын дозаларын белгілейді.

Қоректік ортаны таңдау
Әрбір өндіруші үшін белгілі бір талаптарға сай болуы керек оңтайлы орта жасалады:
а) антибиотиктің максималды шығуын қамтамасыз ету;
б) салыстырмалы түрде арзан компоненттерден тұрады;
в) жақсы сүзу қабілеті бар;
г) антибиотиктерді бөлу және тазарту үшін неғұрлым үнемді тәсілдерді қолдануды қамтамасыз ету.

1. Антибиотиктер жануарлар мен құстарды емдеу үшін қолданылады;
2. Азық антибиотиктері жануарлар мен құстарды тамақтандыру үшін қолданылады.
3. Антибиотиктер өсімдік шаруашылығында өсімдік ауруларымен күресу үшін қолданылады, антибиотиктер гербицидтер, инсектицидтер ретінде қолданылады және химиялық заттарға қарағанда бірқатар артықшылықтарға ие.
- Іс жүргізу
- Автоматтандыру, Техника
- Алғашқы әскери дайындық
- Астрономия
- Ауыл шаруашылығы
- Банк ісі
- Бизнесті бағалау
- Биология
- Бухгалтерлік іс
- Валеология
- Ветеринария
- География
- Геология, Геофизика, Геодезия
- Дін
- Ет, сүт, шарап өнімдері
- Жалпы тарих
- Жер кадастрі, Жылжымайтын мүлік
- Журналистика
- Информатика
- Кеден ісі
- Маркетинг
- Математика, Геометрия
- Медицина
- Мемлекеттік басқару
- Менеджмент
- Мұнай, Газ
- Мұрағат ісі
- Мәдениеттану
- ОБЖ (Основы безопасности жизнедеятельности)
- Педагогика
- Полиграфия
- Психология
- Салық
- Саясаттану
- Сақтандыру
- Сертификаттау, стандарттау
- Социология, Демография
- Спорт
- Статистика
- Тілтану, Филология
- Тарихи тұлғалар
- Тау-кен ісі
- Транспорт
- Туризм
- Физика
- Философия
- Халықаралық қатынастар
- Химия
- Экология, Қоршаған ортаны қорғау
- Экономика
- Экономикалық география
- Электротехника
- Қазақстан тарихы
- Қаржы
- Құрылыс
- Құқық, Криминалистика
- Әдебиет
- Өнер, музыка
- Өнеркәсіп, Өндіріс
Қазақ тілінде жазылған рефераттар, курстық жұмыстар, дипломдық жұмыстар бойынша біздің қор #1 болып табылады.



Ақпарат
Қосымша
Email: info@stud.kz